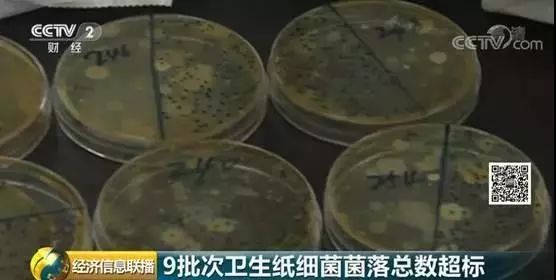
生活中用纸不规范现象的研究报告,央视曝光卫生用品不合格

各位小伙伴们你们吃完饭是否会用纸擦嘴呢?(心里还想着:这下嘴可算擦干净了~)
可是你们知不知道
生活用纸竟有24%不合格!!!
前不久,江苏省市场监督管理局联合南京市产品质量监督检验院对一些网上和实体店销售的卫生纸、纸巾等生活用纸,进行了抽查。
其中
内装量不足、卫生不达标等
老问题依然存在

在检测的150批次样品中,纸巾纸有75批次,卫生纸有75批次。检测结果显示:
共有36批次不合格,不合格率为24%。其中,不合格纸巾纸有21批次,主要存在的问题,是内装量指标不合格,也就是说,纸的实际抽数达不到外包装上显示的数量。
19批次样品
内装量不合格
记者统计后看到,有14批次从电商平台采购。包括标称为:
“亚芳”本色系列抽纸;
“富尔雅”抽取式面巾纸;
“欣蜜儿”抽式面巾纸等。

5批次从实体店采购,包括标称为:
“林露”抽取式面巾纸:
“梦相连”抽取式面巾纸:
“天之楠”压花面巾纸等。

这些不合格的纸巾纸,有的一包少2抽,有的一包少12张,相对于每包几百张的总数来说,消费者其实很难察觉。

江苏省纸张印刷产品质检站检验员贾娟接受采访时表示:
这款是按整箱销售的,一箱是30包,它月销量900万包,它的一包是少了12张,这样子乘下来的话,它的月销量,缺斤少两大概有少了36万包。

9批次样品
严重不合格
在不合格卫生纸中,有9批次细菌菌落总数超标,占比高达60%。检测人员告诉记者,这意味着卫生纸“不卫生”,属于严重不合格。
江苏省纸张印刷产品质检站检验员李晓旸:
本次抽查中像这款产品,它的细菌菌落总数最高限值达到了7800cfu每克,而国家标准规定的最大限值是600cfu每克,超过了国家标准13倍。

9批次不卫生的卫生纸,包括标称为:
“永星” 高级绉纹卫生纸;
“洁通”卫生纸;
“肤之友” 原浆卫生纸;
“徐阳” 本色压花卫生纸;
“洁伴”平板卫生纸的两批次样品等。

对此,江苏省市场监管局对不合格产品销售企业,责令下架,责令不合格产品生产企业,停止生产和销售不合格产品,限期整改,直至复查检验合格。
来源:央视财经